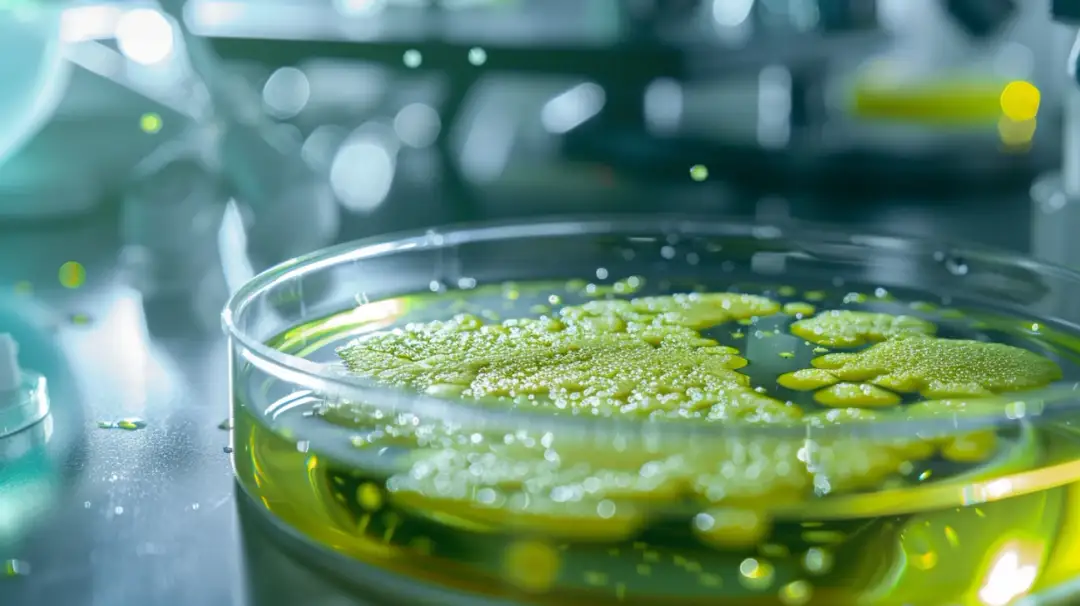
Clostridium difficile - groźne objawy zakażenia bakterią

Pasożyty jelitowe - jakie badania wykonać w diagnostyce?
Dowiedz się, jakie badania należy wykonać w celu prawidłowej diagnostyki pasożytów jelitowych. Przegląd metod, takich jak badanie kału, krwi i obrazowanie dla wczesnego wykrycia infekcji.

Dowiedz się, jakie badania należy wykonać w celu prawidłowej diagnostyki pasożytów jelitowych. Przegląd metod, takich jak badanie kału, krwi i obrazowanie dla wczesnego wykrycia infekcji.

Dowiedz się, co to zaparcia, jakie są ich główne przyczyny i objawy wymagające pomocy lekarza. Poznaj skuteczne domowe sposoby zapobiegania zaparciom i porady, jak radzić sobie z nimi u dzieci.

Dowiedz się, co znaczy low w różnych kontekstach. Poznaj znaczenie terminu "low" w relacjach międzyludzkich, w kontekście energii i samopoczucia oraz hierarchii.


Rozpoznaj prawdziwą przyczynę bólu brzuszka dziecka i skutecznie mu przeciwdziałaj. Poznaj domowe sposoby na ból brzucha u 2-latka oraz sytuacje wymagające wizyty u lekarza. Co na ból brzucha u dwulatka działa najlepiej?

Poznaj niesamowite korzyści, jakie dają probiotyki dla Twojego zdrowia. Co dają probiotyki? Wzmocnienie układu odpornościowego, lepsze trawienie i zdrowa mikroflora jelitowa to tylko niektóre z ich licznych dobrodziejstw.

Poznaj kluczowe różnice między chorobami bakteryjnymi a wirusowymi, ich charakterystykę, objawy i metody leczenia. Dowiedz się, jak skutecznie zapobiegać tym zmaganiom zdrowotnym.
Clostridium difficile objawy to groźne infekcje jelitowe. Poznaj przyczyny i czynniki ryzyka zakażenia tą bakterią, charakterystyczne objawy oraz sposoby leczenia.

Czy zmagasz się z uporczywymi bólami brzucha, wzdęciami czy zaburzeniami wypróżnień? To mogą być niepokojące chore jelita objawy sygnalizujące poważniejszy problem. Dowiedz się o przyczynach i leczeniu tych dolegliwości.

Dowiedz się, na czym polega badanie żywej kropli krwi i dlaczego warto je wykonać. Ta nieinwazyjna metoda pozwala przyjrzeć się komórkom krwi pod mikroskopem i wykryć potencjalne niedobory oraz nieprawidłowości